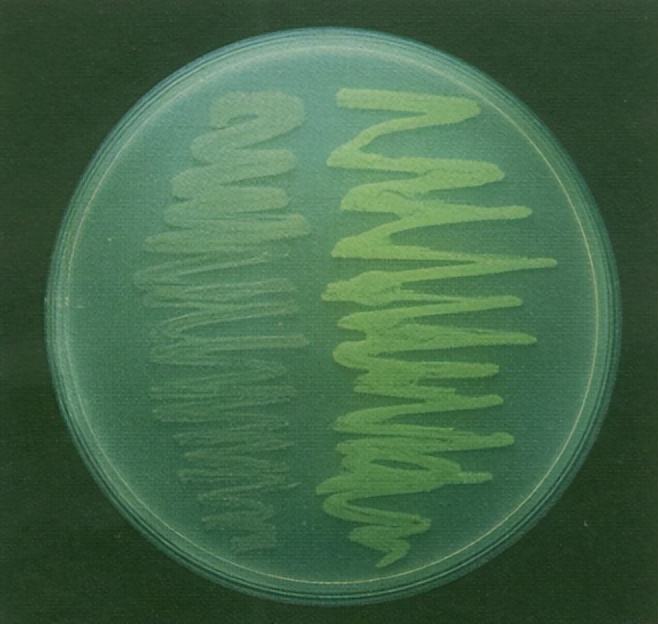
要永远相信光！借1.6亿年前的微光，3个人点亮了这个世纪

点击关注不迷路 ↑ ↑
普及科学知识,传播科学精神

“过去的十年里,绿色荧光蛋白就像明灯,为无数生物化学家、生物学家、医学科学家和其他研究人员指明道路。”
—— 2008年,诺贝尔奖官方新闻

图片来源:The Nobel Foundation
▲2008年的诺贝尔化学奖由三位科学家分享,分别是下村脩(Osamu Shimomura)、Martin Chalfie和钱永健(Roger Y. Tsien),他们为绿色荧光蛋白GFP的发现和开发做出了重要贡献
10万只发光水母
1961年的初夏,33岁的下村脩带着新婚不久的妻子驱车5000公里到达了华盛顿州圣胡安岛的“星期五港”(Friday Harbor)。这里平静安宁,风光旖旎,海岸的岩石上散落着五颜六色的海胆和大小不一的海星,钓上来的石斑鱼做成生鱼片也非常鲜美。
不过,这不是一场新婚蜜月旅行。作为一名刚进普林斯顿大学的博士后,下村正在试图解决一个问题:为什么发光水母( Aequorea victoria )会发光?

▲宁静的星期五港(图片来源:参考资料[3])
这种水母在星期五港非常多,它们受到刺激时,外缘会发出一圈绿色的光。整个夏天,下村带着妻子、同事不断捞取发光水母,一一剪下水母的边缘,然后研磨、过滤,试图从中提取发光物质。
不过,实验一开始很不顺利,下村尝试了各种条件,始终没有找到预想的发光物质。
正当毫无头绪之时, 下村将水母提取液倒入水槽时突然看到,水槽里发出了亮蓝色的闪光 。由于水族箱漏水,一些海水流进了水槽。下村脩意识到,是海水的某种成分激发了发光反应。猜测很快通过实验证实,海水里的钙离子是发光的必要条件。
获得这个关键线索后,接下来的时间里,下村和他实验室的负责人弗兰克·约翰逊(Frank Johnson)终于从10万只发光水母中鉴定出了发光物质的活性成分,将它命名为 水母发光蛋白(aequorin) 。这种蛋白遇到极少量的钙离子,便会发出蓝光,是人类有史以来发现的第一个发光蛋白。

▲一只发光水母(Aequorea victoria)在日光下的颜色和在黑暗室内被刺激时的颜色(图片来源:参考资料[3])
他们在1962年发表的论文里,详细描述了水母发光蛋白的发现过程,并且“顺便”提到,同时发现和纯化出了另一种含量少得多的“绿色蛋白”——就是后来的 绿色荧光蛋白 (GFP)。
相比水母发光蛋白,GFP的结构显得比较“简单”。它由238个氨基酸组成,它们串成一条长链,弯曲折叠成一个桶状结构,位于“桶”内的三个氨基酸相互作用,构成了特殊的发色团(chromophore)。GFP的发色团吸收了水母发光蛋白发出的蓝光,然后释放出绿光,也就是发光水母发出绿光而不是蓝光的原因。
灵“光”乍现
在发光水母的体内,GFP的存在时间超过了1.6亿年 ,它们发出的光将照亮21世纪的生物学。不过,在被下村发现它们的存在之后,GFP还要再等30年才开始大放异彩。
时间来到1989年,哥伦比亚大学的马丁·查尔菲(Martin Chalfie)在系里例行的午餐研讨会上,头一回听说了水母发光蛋白和绿色荧光蛋白的存在。这让他眼睛一亮,立刻在笔记本上记录了荧光蛋白的知识。
值得一提的是,马丁早期的学术生涯可能会让一些研究生产生共鸣,他最初完全不知道自己要研究什么,他做过抗肿瘤药物研究,也尝试过修饰氨基酸研究,最后都做不出像样的结果,干脆还自暴自弃跑去研究社会科学。

▲马丁与自己的第一把吉他,他曾表示要是自己没什么科学成就可能会去做吉他手(图片来源:参考资料[6])
退出实验室后,他还去当过中学老师,但是刚当了一年又觉得不合适重新回到了实验室。为了毕业论文能顺利产出,马丁又是从这个实验室换到那个实验室,他在室友的帮助下学会了培养秀丽隐杆线虫,这也不知不觉给GFP的应用铺好了路。
线虫的一个特点是全身透明,因此如果绿色荧光蛋白放入线虫身体里,不仅可以看到哪里放光了,还可以作为一种标记工具。
按照他的设想,把编码GFP的基因与编码其他蛋白质的基因连接起来,或是与控制其他基因的启动子(相当于“基因开关”)连接起来,就能以绿色荧光为指示信号,看到其他蛋白质在哪里产生,或是细胞里的基因开关在什么时候打开。
这个点子很妙,但要实现它,第一步需要在发光水母的基因组里找到GFP基因,然后将其分离出来,也就是所谓的“克隆”这个基因。
马丁打听到Woods Hole海洋研究所的道格拉斯·普瑞舍(Douglas Prasher)正在做克隆GFP基因的工作,并且也有使用GFP标记蛋白的类似想法。经过交流,两人决定展开合作。
几年后,道格拉斯成功完成了GFP基因的克隆工作,他慷慨地把带有基因的质粒寄给了马丁以及很多对此感兴趣的科学家。
▲表达了GFP的大肠杆菌(图片来源:参考资料[4])
正如马丁满心期待的那样,当他和同事把编码GFP的基因片段设法放入大肠杆菌的细胞后,他们看到,在紫外灯的照射下, 大肠杆菌发出了令人激动的绿色荧光 !这个关键的实验证明,在大肠杆菌的细胞中,无需任何其他辅助因子,GFP蛋白的发色团就可以自发形成。
紧接着,马丁在他熟悉的线虫身上尝试了一个新实验,把GFP作为基因表达的标记物。借助DNA技术,他把编码GFP的基因放置在一段启动子后面,这段启动子只在负责触觉的6个神经元中活跃。

▲表达了GFP的线虫(图片来源:参考资料[4])
实验再次成功!一条全身透明、几个神经细胞呈现亮绿色的线虫,登上了1994年2月的《科学》杂志的封面。

图片来源:参考资料[4],Science官网截图
▲1994年2月的《科学》杂志以封面文章的形式报道了马丁及其合作者的GFP实验结果
马丁的实验结果迅速引起了很多人的兴趣,以GFP为核心的一场技术革新出现了。
从荧光绿到万花筒
和马丁一样,加州大学圣地亚哥分校(UCSD)的钱永健(Roger Tsien)博士也从道格拉斯那里获赠了带有GFP基因的质粒。
钱永健博士擅长应用化学来解决生物问题。但这在工作申请中却成了麻烦,因为生物系认为他是一个化学家,而化学系拒绝他研究生物问题。
幸运的是,这种跨学科的兴趣最终让GFP革命有了巨大的飞跃。
深入研究了GFP发色团的化学结构后,钱永健博士借助DNA技术对GFP的氨基酸组成进行了改造。通过随机突变,他和同事们开发出了几种新版本的绿色荧光蛋白,包括发光更强烈的增强型GFP,以及蓝色、青色和黄色的荧光蛋白。

▲表达四种GFP突变体、发出不同颜色的大肠杆菌(图片来源:参考资料[2])
此后,俄罗斯的一个实验室在珊瑚虫中寻找类似GFP的蛋白质时,找到了一种发红光的蛋白DsRED。再一次,钱永健博士带领研究小组对DsRED进行了改造,使这种蛋白变得更稳定、更适宜与其他蛋白质连接,可以像GFP一样进入细胞作为生物过程的荧光标记。
现在,调色板上的颜色越来越多了。在修改版DsRED的基础上,钱永健的研究小组开发了一系列 彩色荧光蛋白 ,根据它们发光的颜色,这些荧光蛋白被命名为梅子(mPlum)、樱桃(mCherry)、草莓(mStrawberry)、橘子(mOrange),等等。

▲彩色荧光蛋白(图片来源:参考资料[5])
这些丰富多彩的颜色,让原本肉眼难以看见的生物过程变得骤然清晰、生动起来。荧光蛋白照亮了正在生长的肿瘤,曝光了致病细菌的行踪,显示出正在因阿尔茨海默病而受伤的神经细胞。
用这些荧光蛋白,科学家们首次看清了活细胞中的病毒颗粒如何组装,看清了大脑中一个个神经细胞如何通过神经纤维构成密集的神经网络,还可以跟踪单个蛋白质在细胞内的运动,以及与其他蛋白质的相互作用。
除此之外,GFP还在更广阔的生物技术应用中发挥作用。例如,基因改造的细菌,可以在有毒金属存在的情况下发出绿光,用于检测水质。

▲使用三种荧光蛋白(黄色、青色和红色),科学家让小鼠大脑变成了万花筒(图片来源:参考资料[1])
2016年8月,绿色荧光蛋白的改造者钱永健博士骤然辞世。2018年10月,发现绿色荧光蛋白的下村脩博士也与世长辞。他们留下的光芒,我们不会忘记。
参考资料:
[1] The Nobel Prize in Chemistry 2008. Retrieved Sep 23th, 2022 from https://www.nobelprize.org/prizes/chemistry/2008/press-release/
[2] The green fluorescent protein: discovery, expression and development. Retrieved Sep 23th, 2022 from https://www.nobelprize.org/uploads/2018/06/advanced-chemistryprize2008-1.pdf
[3] Osamu Shimomura: DISCOVERY OF GREEN FLUORESCENT PROTEIN, GFP https://www.nobelprize.org/uploads/2018/06/shimomura_lecture.pdf
[4] Martin et al., (1994) Green fluorescent protein as a marker for gene expression. Science. DOI: 10.1126/science.8303295
[5] Nathan C Shaner et al., (2004) Improved monomeric red, orange and yellow fluorescent proteins derived from Discosoma sp. red fluorescent protein Nature Biotech. DOI: 10.1038/nbt1037
[6]Martin Chalfie Biographical. Retrieved Sep 23th, 2022 from https://www.nobelprize.org/prizes/chemistry/2008/chalfie/biographical/
免责声明:药明康德内容团队专注介绍全球生物医药健康研究进展。本文仅作信息交流之目的,文中观点不代表药明康德立场,亦不代表药明康德支持或反对文中观点。本文也不是治疗方案推荐。如需获得治疗方案指导,请前往正规医院就诊。